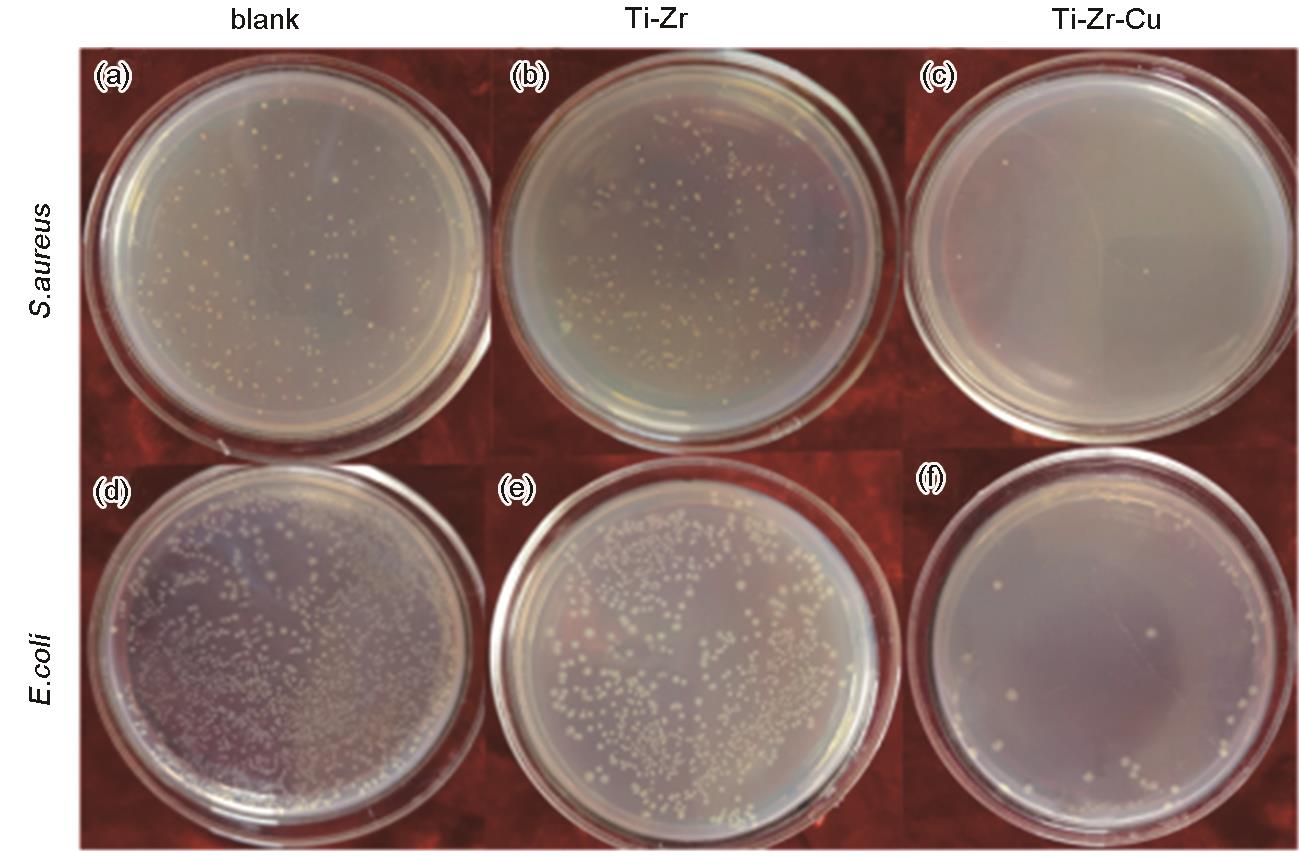

Ti-Zr-Cu合金的抗菌性能和体外生物相容性
Antibacterial Property and in vitro Biocompatibility of a Ti-Zr-Cu Alloy

Ti-Zr-Cu合金的抗菌性能和体外生物相容性 |
| 于佳莹, 杨希祥, 战德松, 杨柯, 任玲, 王敬人, 徐嘉蔚 |
|
Antibacterial Property and in vitro Biocompatibility of a Ti-Zr-Cu Alloy |
| YU Jiaying, YANG Xixiang, ZHAN Desong, YANG Ke, REN Ling, WANG Jingren, XU Jiawei |
| 图1 金黄色葡萄球菌(S. aureus)和大肠杆菌(E. coli)分别与Ti-Zr合金和Ti-Zr-Cu合金共培养24 h后存活细菌菌落的照片 |
| Fig.1 Photos of colonies of S. aureus and E. coli after co-culture with Ti-Zr alloy and Ti-Zr-Cu alloy for 24 h (a) blank group (S. aureus); (b) Ti-Zr (S. aureus); (c) Ti-Zr-Cu (S. aureus); (d) blank group (E. coli); (e) Ti-Zr (E. coli); (f) Ti-Zr-Cu (E. coli) |
|